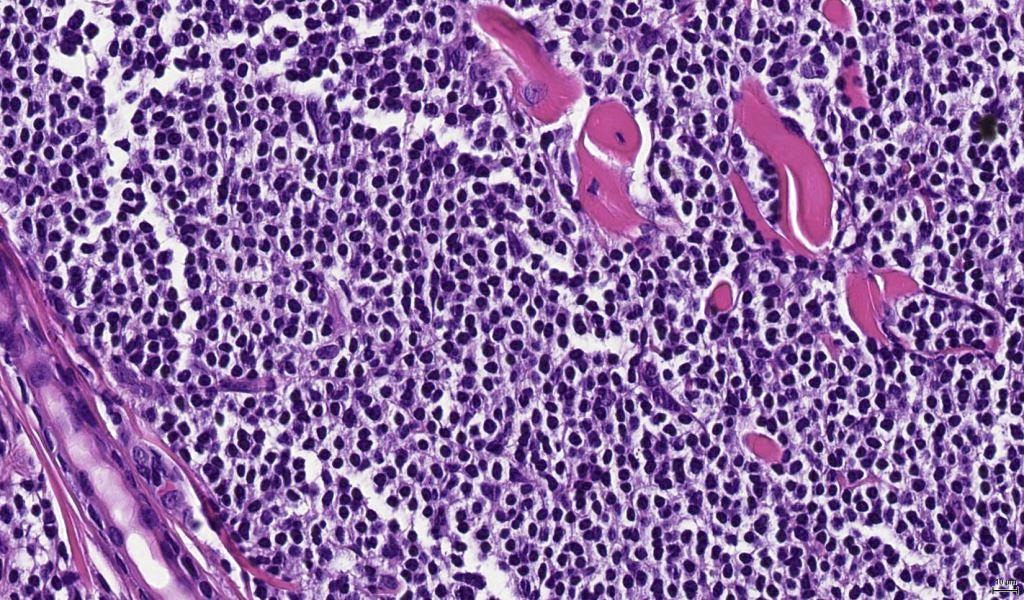

Table of Contents
Definition / general | Essential features | Terminology | ICD coding | Epidemiology | Sites | Etiology | Clinical features | Diagnosis | Laboratory | Prognostic factors | Case reports | Treatment | Clinical images | Microscopic (histologic) description | Microscopic (histologic) images | Virtual slides | Positive stains | Negative stains | Molecular / cytogenetics description | Sample pathology report | Differential diagnosis | Practice question #1 | Practice answer #1 | Practice question #2 | Practice answer #2Cite this page: LeBlanc RE. Primary cutaneous marginal zone lymphoma / lymphoproliferative disorder. PathologyOutlines.com website. https://www.pathologyoutlines.com/topic/skintumornonmelanocyticmalt.html. Accessed September 17th, 2025.
Definition / general
- B cell lymphoma derived from mature, predominantly postgerminal center B cells
- Subsumed under the 2016 revised World Health Organization classification of extranodal marginal zone B cell lymphoma of mucosa associated lymphoid tissue (MALT lymphoma) (Blood 2016;127:2375)
- Nodule or coalescing papules on the torso or upper extremities; lesions are often localized
- Excellent overall survival with rare reports of transformation to a more aggressive phenotype
Essential features
- Primary cutaneous marginal zone B cell lymphoma (CMZL) is an indolent lymphoma with a nonspecific postgerminal center B cell phenotype that often presents as coalescing papules or a nodule on the torso or upper extremity of middle aged adults
- Excellent prognosis, rarely disseminates beyond skin and exceptionally rare cases show progression to an aggressive blastic or large cell appearance
- Comprised of 2 subtypes with distinct histomorphologic findings, a nonclass switched subtype that shares many similarities with extracutaneous marginal zone lymphomas and a class switched subtype that may be accompanied by a preponderance of reactive T and B lymphocytes
- Colonization of germinal center follicles by lymphoma is a helpful feature for making the diagnosis; however, CMZL should never exhibit a germinal center immunophenotype and should not be comprised of large and mitotically active cells
- Demonstration of a light chain restriction by in situ hybridization (or immunohistochemistry) or a clonally rearranged immunoglobulin heavy chain gene by PCR is more common in CMZL than in reactive cutaneous lymphoid hyperplasias; however, clonality is not pathognomonic of lymphoma
Terminology
- Extranodal marginal zone B cell lymphoma of mucosa associated lymphoid tissue (MALT lymphoma)
ICD coding
- C88.4: extranodal marginal zone B cell lymphoma of mucosa associated lymphoid tissue (MALT lymphoma)
Epidemiology
- Young to middle aged men and women, rare childhood cases
- Approximately 30% of cutaneous B cell lymphoma
Sites
- Variable but most frequently involves the trunk and upper extremities
- Many lesions are solitary or localized / regional; generalized spread in a minority of cases
- Extracutaneous dissemination is exceptional and should raise suspicion for cutaneous dissemination of an extracutaneous lymphoma (e.g. of splenic or nodal origin)
Etiology
- Etiology is poorly understood, although thought to evolve in the setting of cutaneous lymphoid hyperplasia resulting from a variety of antigenic triggers
- Chronic antigenic stimulation may lead to immune dysregulation (analogous to the role of chronic Helicobacter pylori infection in the pathogenesis of gastric MALT lymphoma) (J Cutan Pathol 1997;24:457)
- Two distinct subcategories
- Nonclass switched
- More closely resembles extracutaneous MZL in that it arises in the setting of chronic Th1 type inflammation with increased production of Th1 associated cytokines including IFNƴ and IL2 (Blood 2008;112:3355)
- Borrelia burgdorferi antigen has been identified in a subset of cases from Europe but not in cases from the U.S. or Japan (J Cutan Pathol 1997;24:457, Am J Surg Pathol 2000;24:1279)
- Heavy chain class switched
- Majority of cutaneous MZL, is histologically distinct from extracutaneous MZL and arises in the setting of chronic Th2 type inflammation
- May arise in individuals with an allergic or atopic diathesis (Am J Surg Pathol 2010;34:1830)
- Nonclass switched
- Some cases associated with medications including methotrexate, cyclosporine, antidepressants and antihistamines (J Cutan Pathol 2006;33:1)
- Infectious disease associations have also included Helicobacter pylori, Hepatitis C and Epstein Barr virus
- Autoimmune disease associations include polyarteritis nodosa, Sjögren syndrome, rheumatoid arthritis, Hashimoto thyroiditis and ulcerative colitis (Appl Immunohistochem Mol Morphol 2004;12:216)
- Recurrent mutations involving FAS that affected the death domain of the apoptosis regulating FAS / CD95 protein were recently identified in 24 of 38 cases (J Invest Dermatol 2018 Feb 23 [Epub ahead of print])
Clinical features
- Erythematous to violaceous nodule or plaque comprised of coalescing papules
Diagnosis
- Clinical correlation (complete history, review of systems, physical examination, complete blood count and imaging studies) are required to exclude skin involvement by lymphoma of extracutaneous origin
Laboratory
- Serologic testing for Borrelia burgdorferi may be helpful for excluding reactive lymphoid hyperplasia within Europe (no demonstrable association between the organism and CMZL in U.S. or Japan)
Prognostic factors
- Excellent 5 year overall survival of > 95%
- Small minority (4%) experience dissemination beyond the skin (J Am Acad Dermatol 2013;69:357)
- Relapse occurs in less than half of patients and is more common in patients with multifocal skin involvement (J Am Acad Dermatol 2013;69:357)
- Rare cases undergo transformation to an aggressive, blastic or large cell phenotype analogous to what is reported in splenic B cell lymphoma (APMIS 2007;115:1426)
Case reports
- 15 year old boy with a 3 cm erythematous plaque on the left forearm (J Cutan Pathol 2006;33:1)
- 33 year old man with chronic active hepatitis B and multiple cutaneous nodules (J Cutan Pathol 2011;38:342)
- 60 year old woman with nodules on both of her elbows (Dermatol Online J 2015;21:qt9s15929m)
Treatment
- Excision, radiotherapy and intralesional steroids for skin limited localized disease
- Withdrawal of any agent associated with this disease, often an antihistamine or antidepressant, could also be considered
Microscopic (histologic) description
- In general, CMZL exhibits a nodular and diffuse architecture described as having a grenz zone and a bottom heavy appearance (no tapering with descent to the deep dermis and superficial subcutis)
- Neoplastic B cells can have 3 appearances
- Monocytoid appearance
- Cleaved nuclei reminiscent of centrocytes
- Small round cells reminiscent of CLL / SLL
- Plasma cells and plasmacytoid cells may be conspicuous at the periphery of dermal nodules
- Nonclass switched CMZL often has dense sheets and nodules filling the dermis
- Class switched CMZL often has a preponderance of T cells and reactive germinal B cell follicles accompanying the neoplastic B cell population, which ranges in appearance from dense nodules to perivascular infiltrates or sometimes sparse, scattered cells
- Class switched CMZL can show variable plasmacytic differentiation and extreme examples were formerly called immunocytoma (dense perivascular plasma cell aggregates and binucleated forms, nuclear pleomorphism and Dutcher bodies are helpful hints to this diagnosis)
Microscopic (histologic) images
Positive stains
- Kappa or lambda light chain restriction in plasma cells or plasmacytoid forms has greater sensitivity for the detection of B cell monoclonality in CMZL than PCR detection of clonal IGH rearrangement
- B cells most often exhibit a mature, postgerminal center immunophenotype
- CD20 (may not be detected in patients who have received rituximab)
- CD79a
- BCL2
- CD43 (not always expressed)
- Colonization of germinal center follicles by neoplastic B cells (lymphoma cells are present within former germinal center follicles delineated by CD21 positive follicular dendritic cell networks and may surround diminished germinal centers that express BCL6 and CD10)
- T cells can may outnumber B cells and show a preponderance of CD4 positive forms with numerous cells expressing T follicular helper markers (PD-1 and BCL6)
- CXCR3, while not necessary for diagnosis, is more likely to be expressed in nonclass switched CMZL (Th1 dominant) along with IgM (the same as extracutaneous MZL)
- CXCR3 is less likely to be expressed in class switched CMZL (Th2 dominant) along with IgG (most cases) and or other isotypes in a minority of cases (Blood 2008;112:3355)
Negative stains
Molecular / cytogenetics description
- Clonal rearrangement of the immunoglobulin heavy chain supports the diagnosis; however, this test suffers from low sensitivity owing to the fact that a large proportion of the infiltrate can be comprised of reactive T and B cells
- Trisomy 3 is present in at least 60% (Blood 1995;85:2000) with trisomy 7, 12 and 18 in a smaller subset of cases
- Rare cases show t(11;18)(q21;q21) resulting in API2-MALT1 fusion
- Rare cases show t(14;18) involving IGH / BCL2 or IGH / MLT1 (Am J Surg Pathol 2003;27:702)
- Report of t(3;14) IGH - FOXP1 (Leukemia 2005;19:652)
- 7q deletions, which can also be seen in some splenic lymphomas, have been described in a subset of cases including ones that underwent transformation to an aggressive blastic phenotype (Am J Dermatopathol 2013;35:319)
Sample pathology report
- Skin, left upper chest, excision:
- Clonal B cell infiltrate, suspicious for cutaneous marginal zone lymphoma (see comment)
- Comment: The dense dermal infiltrate comprised of small, mature B cells colonizes germinal center follicles. In the provided context of a solitary nodule on the chest of an adult, the immunophenotype and evident lambda light chain restriction provide support for a diagnosis of primary cutaneous marginal zone lymphoma. Correlation with clinical features is essential in order to confirm this impression.
Differential diagnosis
- Chronic lymphocytic leukemia / small lymphocytic lymphoma: CD5+ / CD23+
- Cutaneous lymphoid hyperplasia: clinical correlation helpful
- Does not usually have a bottom heavy infiltrate
- No light chain restriction or clonal IGH rearrangement
- Preservation of germinal center follicles
- Diffuse large B cell lymphoma: preponderance of large B cells with increased mitotic activity and Ki67 proliferation rate; B cells predominate in the infiltrate
- Follicular lymphoma: clinical correlation, BCL2+ cells that co-express germinal center B cell markers (CD10, STMN1, HGAL, LMO2) extending beyond CD21+ dendritic cell networks in contrast to colonization of germinal center follicles present in CMZL
- Lymphoplasmacytic lymphoma: rare reports in the skin
- Clinical correlation is required
- LPL can be challenging to distinguish from CMZL with extensive plasmacytic differentiation as they share a similar immunophenotype and the latter can rarely produce Waldenström macroglobulinemia
- Mantle cell lymphoma: cyclin D1+
- Myeloma (plasmacytoma): clinical correlation
- Primary cutaneous CD4 positive small / medium sized pleomorphic T cell lymphoproliferative disorder: clinical correlation may be necessary to distinguish from T cell rich CMZL
- Usually a solitary lesion on the head and neck of a middle aged woman
- Clonally rearranged T cell receptor
- No B cell clone by immunohistochemistry or clonal IGH rearrangement
- High percentage of PD-1+ cells including enlarged forms (Am J Surg Pathol 2010;34:1830)
- Primary cutaneous follicle center lymphoma: BCL6+ cells or less frequently BCL2+ cells that co-express germinal center B cell markers (CD10, STMN1, HGAL, LMO2) extending beyond CD21+ dendritic cell networks in contrast to colonization of germinal center follicles present in CMZL
- Pseudolymphomatous folliculitis: clinical correlation helpful
- Folliculocentric mixed inflammatory infiltrate
- Often with perivascular granulomas and florid reactive follicular epithelial changes reminiscent of pseodueptheliomatous hyperplasia
- Splenic lymphoma: clinical correlation required, cases with cutaneous involvement can be indistinguishable from CMZL (Histopathology 2002;40:22)
- Tumid lupus erythematosus: clinical correlation, periadnexal and perivascular inflammation with interstitial mucin deposition and superficial dermal edema
Practice question #1
Which of the following stains highlight only B cells and not the accompanying T cells in a case of T cell rich primary cutaneous marginal zone B cell lymphoma?
- BCL2
- BCL6
- CD79a
- PD-1
Practice answer #1
C. CD79a. BCL2 can be challenging to evaluate as it will highlight both the neoplastic B cells comprising marginal zone lymphoma as well as accompanying T lymphocytes. Cases of T cell rich marginal zone lymphoma can contain a substantial population of T cells exhibiting a T follicular helper immunophenotype with variable expression of PD-1 and BCL6. These markers should not be expressed in the neoplastic B cells of marginal zone lymphoma.
Comment Here
Reference: Cutaneous marginal zone lymphoma / MALT
Comment Here
Reference: Cutaneous marginal zone lymphoma / MALT
Practice question #2
Which of the following findings favors the diagnosis of primary cutaneous follicle center lymphoma over primary cutaneous marginal zone B cell lymphoma?
- B cells with a germinal center phenotype extending beyond CD21+ dendritic cell networks
- Confluent Ki67 expression by neoplastic B cells throughout the germinal center follicles
- Presence of circumscribed dermal aggregates
- Presence of kappa light chain-restricted plasma cells
Practice answer #2
A. B cells with a germinal center immunophenotype extend beyond CD21 positive dendritic cell networks in primary cutaneous follicle center lymphoma. This is distinct from colonization of germinal center follicles present in some cases of marginal zone lymphoma. Circumscribed, nodular dermal aggregates can be identified in both lymphomas. A kappa light chain-restricted plasma cell population could be seen in marginal zone lymphoma. Lastly, Ki67 staining appears decreased in neoplastic germinal centers of follicle center lymphoma.
Comment Here
Reference: Cutaneous marginal zone lymphoma / MALT
Comment Here
Reference: Cutaneous marginal zone lymphoma / MALT